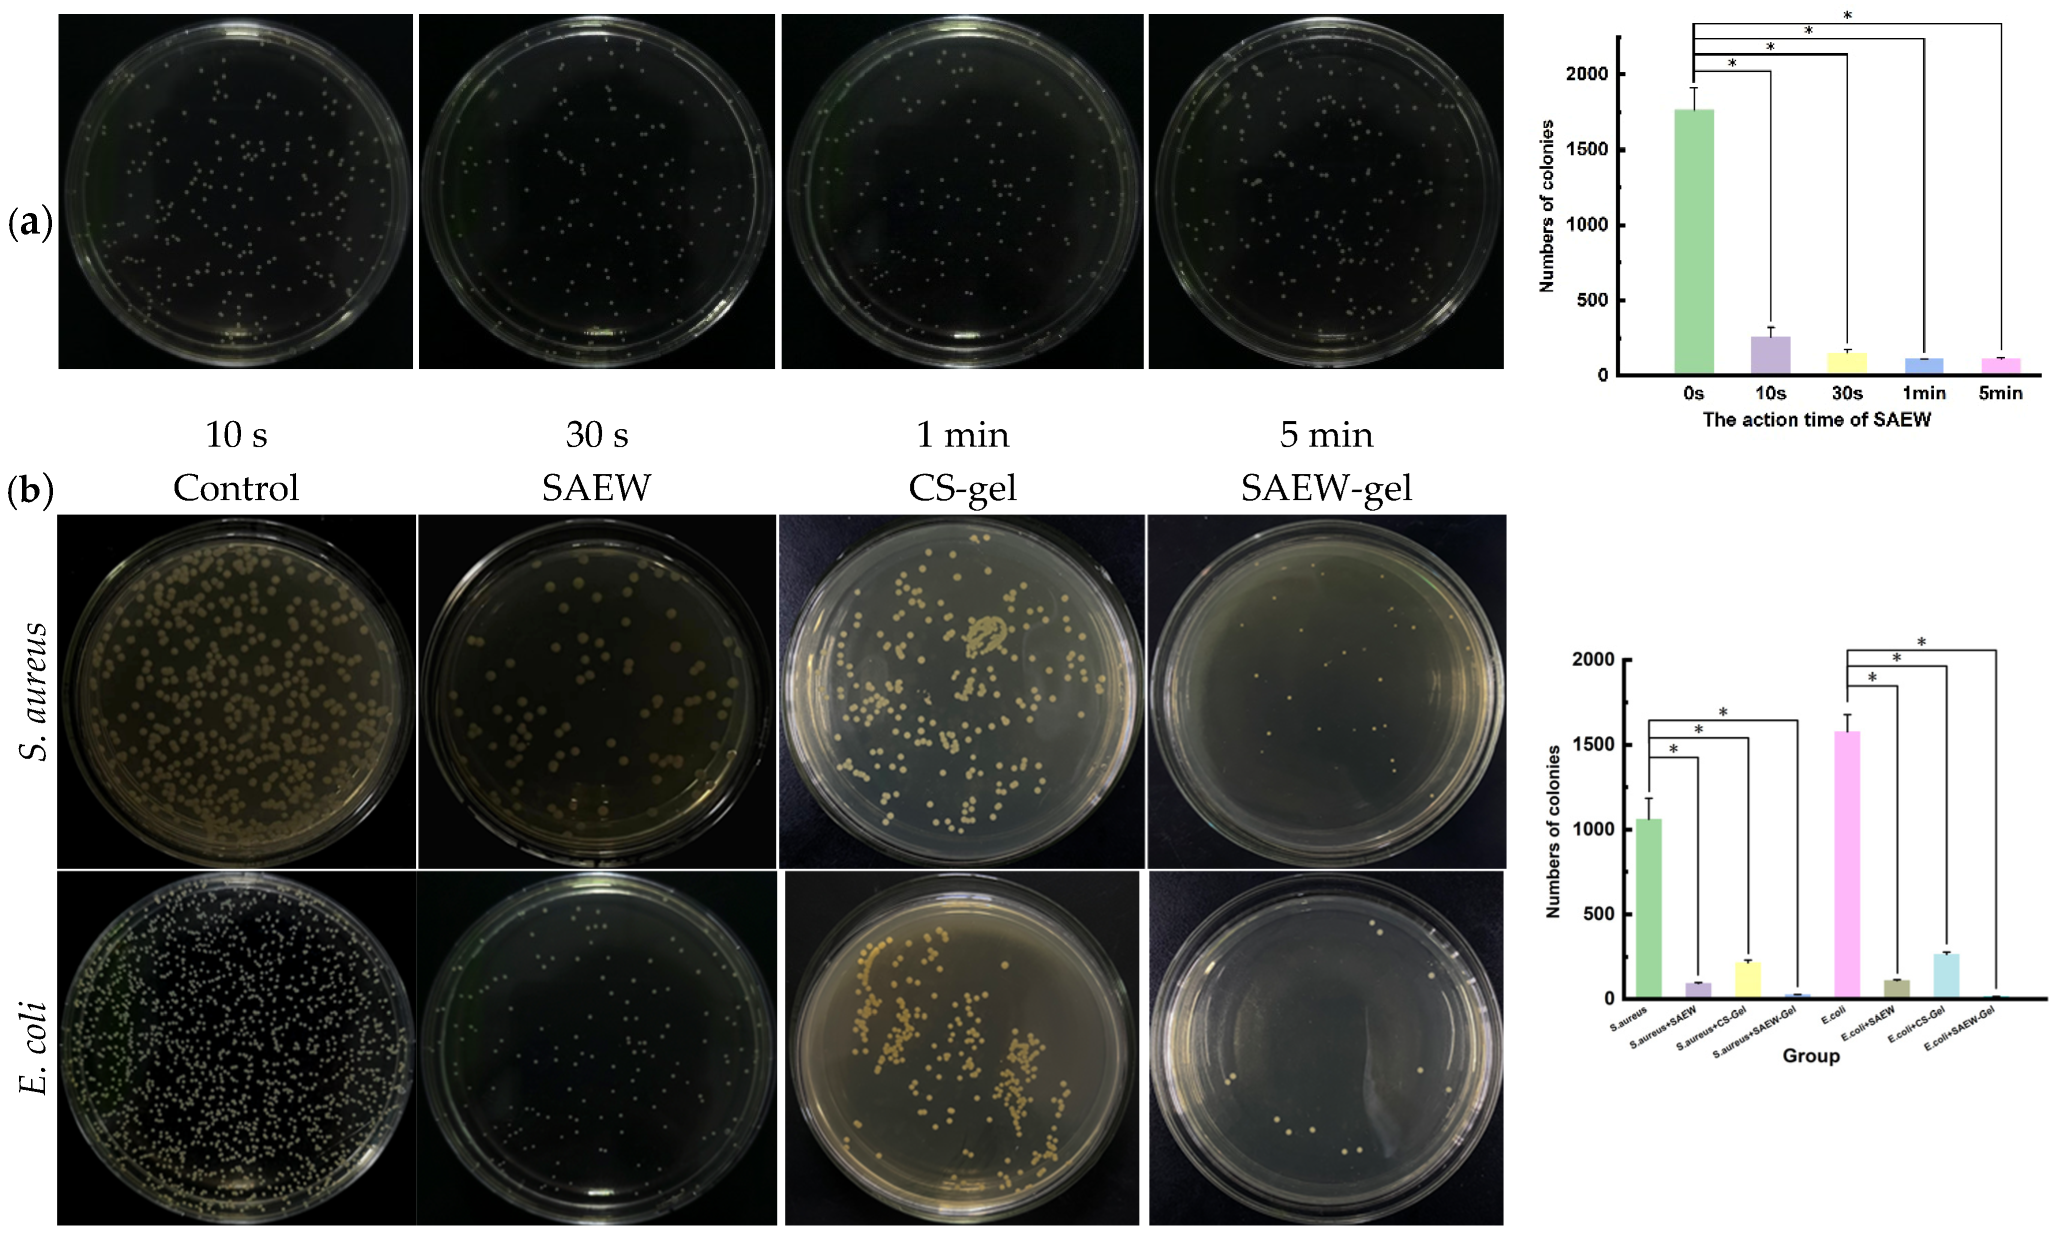
Ijms 26 05908 g002

Combination of Slightly Acidic Electrolyzed Water and Hydrogel to Enhance Stability, Increase Antibacterial Efficacy, and Promote Infectious Wound Healing
Abstract
1. Introduction
2. Results and Discussion
2.1. Properties of SAEW and SAEW-Gel
2.2. Evaluation of Antibacterial Activity In Vitro
2.3. Stability of SAEW-Gel
2.4. Evaluation of Promoting Healing Effect on Skin Wounds
2.5. Pathological Observation of Skin Wounds
2.6. Detection of Bacterial Load in Skin Wound
2.7. Determination of Inflammatory Factors, Anti-Inflammatory Factors, and Collagen in Skin Wound Tissue
3. Materials and Methods
3.1. Materials
3.2. Preparation of SAEW
3.3. Stability Investigation of SAEW
3.4. Preparation of SAEW-Gel
3.5. Appearance and SEM Observation of Gel
3.6. Antibacterial Effect In Vitro of SAEW-Gel
3.7. Swelling Test
3.8. Water Retention Test
3.9. Stability Investigation of SAEW-Gel
3.10. Evaluation of Promoting Healing Effect on Skin Wounds
4. Conclusions
Author Contributions
Funding
Institutional Review Board Statement
Informed Consent Statement
Data Availability Statement
Acknowledgments
Conflicts of Interest
References
- Xie, J.Y.; Huang, X.; Hu, X. A Constant Filgotinib Delivery Adhesive Platform Based on Polyethylene Glycol (PEG) Hydrogel for Accelerating Wound Healing via Restoring Macrophage Mitochondrial Homeostasis. Small 2025, 21, 2408791. [Google Scholar] [CrossRef] [PubMed]
- Qi, X.; Li, Y.; Xiang, Y.; Chen, Y.; Shi, Y.; Ge, X.; Zeng, B.; Shen, J. Hyperthermia-enhanced immunoregulation hydrogel for oxygenation and ROS neutralization in diabetic foot ulcers. Cell Biomater. 2025, 1, 100020. [Google Scholar] [CrossRef]
- Johnson, A.C.; Buchanan, E.P.; Khechoyan, D.Y. Wound infection: A review of qualitative and quantitative assessment modalities. J. Plast. Reconstr. Aes. 2022, 75, 1287–1296. [Google Scholar] [CrossRef] [PubMed]
- Liu, C.; Zheng, W.; Li, Z.; Zhou, L.; Sun, Y.; Han, S. Slightly acidic electrolyzed water as an alternative disinfection technique for hatching eggs. Poult. Sci. 2022, 101, 101643. [Google Scholar] [CrossRef]
- Zang, Y.T.; Bing, S.; Li, Y.J.; Shu, D.Q. Application of slightly acidic electrolyzed water and ultraviolet light for Salmonella enteritidis decontamination of cell suspensions and surfaces of artificially inoculated plastic poultry transport coops and other facility surfaces. Poult. Sci. 2019, 98, 6445–6451. [Google Scholar] [CrossRef]
- Xuan, X.; Fan, Y.; Ling, J.; Hu, Y.; Liu, D.; Chen, S.; Ye, X.; Ding, T. Preservation of squid by slightly acidic electrolyzed water ice. Food Control. 2017, 73, 1483–1489. [Google Scholar] [CrossRef]
- Zhang, C.; Cao, W.; Hung, Y.; Li, B. Disinfection effect of slightly acidic electrolyzed water on celery and cilantro. Food Control 2016, 69, 147–152. [Google Scholar] [CrossRef]
- Suzuki, K.; Nakamura, T.; Kokubo, S.; Tomita, M. The physical properties of slightly acidic electrolyzed water prepared with hydrochloric acid as a raw material. J. Antibact. Antifung. Agents 2005, 33, 55–62. [Google Scholar]
- Issa-Zacharia, A.; Kamitani, Y.; Tiisekwa, A.; Morita, K.; Iwasaki, K. In vitro inactivation of Escherichia coli, Staphylococcus aureus and Salmonella spp. using slightly acidic electrolyzed water. J. Biosci. Bioeng. 2010, 110, 308–313. [Google Scholar] [CrossRef]
- Okanda, T.; Takahashi, R.; Ehara, T.; Ohkusu, K.; Furuya, N.; Matsumoto, T. Slightly acidic electrolyzed water disrupts biofilms and effectively disinfects Pseudomonas aeruginosa. J. Infect. Chemother. 2019, 25, 452–457. [Google Scholar] [CrossRef]
- Xuan, X.T.; Wang, M.M.; Ahn, J.; Ma, Y.N.; Chen, S.G.; Ye, X.Q.; Liu, D.H.; Ding, T. Storage Stability of Slightly Acidic Electrolyzed Water and Circulating Electrolyzed Water and Their Property Changes after Application. J. Food Sci. 2016, 81, E610–E617. [Google Scholar] [CrossRef] [PubMed]
- Cui, X.; Shang, Y.; Shi, Z.; Xin, H.; Cao, W. Physicochemical properties and bactericidal efficiency of neutral and acidic electrolyzed water under different storage conditions. J. Food Eng. 2009, 91, 582–586. [Google Scholar] [CrossRef]
- Hsu, S. Effects of flow rate, temperature and salt concentration on chemical and physical properties of electrolyzed oxidizing water. J. Food Eng. 2005, 66, 171–176. [Google Scholar] [CrossRef]
- Wang, H.; Duan, D.; Wu, Z.; Xue, S.; Xu, X.; Zhou, G. Primary concerns regarding the application of electrolyzed water in the meat industry. Food Control. 2019, 95, 50–56. [Google Scholar] [CrossRef]
- Len, S.V.; Hung, Y.C.; Chung, D.; Anderson, J.L.; Erickson, M.C.; Morita, K. Effects of storage conditions and pH on chlorine loss in electrolyzed oxidizing (EO) water. J. Agr. Food Chem. 2002, 50, 209–212. [Google Scholar] [CrossRef]
- Peers, S.; Montembault, A.; Ladavière, C. Chitosan hydrogels for sustained drug delivery. J. Control Release. 2020, 326, 150–163. [Google Scholar] [CrossRef]
- Cheng, D.; Liu, Y.; Yang, G.; Zhang, A. Water- and Fertilizer-Integrated Hydrogel Derived from the Polymerization of Acrylic Acid and Urea as a Slow-Release N Fertilizer and Water Retention in Agriculture. J. Agr. Food Chem. 2018, 66, 5762–5769. [Google Scholar] [CrossRef]
- Sharma, S.; Kumar, R.; Kumari, P.; Kharwar, R.N.; Yadav, A.K.; Saripella, S. Mechanically magnified chitosan-based hydrogel as tissue adhesive and antimicrobial candidate. Int. J. Biol. Macromol. 2019, 125, 109–115. [Google Scholar] [CrossRef]
- Elviri, L.; Asadzadeh, M.; Cucinelli, R.; Bianchera, A.; Bettini, R. Macroporous chitosan hydrogels: Effects of sulfur on the loading and release behaviour of amino acid-based compounds. Carbohyd Polym. 2015, 132, 50–58. [Google Scholar] [CrossRef]
- Cao, Z.; Luo, Y.; Li, Z.; Tan, L.; Liu, X.; Li, C.; Zheng, Y.; Cui, Z.; Yeung, K.; Liang, Y.; et al. Antibacterial Hybrid Hydrogels. Macromol. Biosci. 2021, 21, e2000252. [Google Scholar] [CrossRef]
- Zhao, F.; Liu, Y.; Song, T.; Zhang, B.; Li, D.; Xiao, Y.; Zhang, X. A chitosan-based multifunctional hydrogel containing in situ rapidly bioreduced silver nanoparticles for accelerating infected wound healing. J. Mater. Chem. B 2022, 10, 2135–2147. [Google Scholar] [CrossRef] [PubMed]
- Mohammed, A.M.; Hassan, K.T.; Hassan, O.M. Assessment of antimicrobial activity of chitosan/silver nanoparticles hydrogel and cryogel microspheres. Int. J. Biol. Macromol. 2023, 233, 123580. [Google Scholar] [CrossRef] [PubMed]
- Ferfera-Harrar, H.; Berdous, D.; Benhalima, T. Hydrogel nanocomposites based on chitosan-g-polyacrylamide and silver nanoparticles synthesized using Curcuma longa for antibacterial applications. Polym. Bull. 2018, 75, 2819–2846. [Google Scholar] [CrossRef]
- Li, Z.; Guan, J. Thermosensitive hydrogels for drug delivery. Expert. Opin. Drug Del. 2011, 8, 991–1007. [Google Scholar] [CrossRef]
- Sheng, X.; Shu, D.; Tang, X.; Zang, Y. Effects of slightly acidic electrolyzed water on the microbial quality and shelf life extension of beef during refrigeration. Food Sci. Nutr. 2018, 6, 1975–1981. [Google Scholar] [CrossRef]
- Liao, X.; Xuan, X.; Li, J.; Suo, Y.; Liu, D.; Ye, X.; Chen, S.; Ding, T. Bactericidal action of slightly acidic electrolyzed water against Escherichia coli and Staphylococcus aureus via multiple cell targets. Food Control. 2017, 79, 380–385. [Google Scholar] [CrossRef]
- Xiang, J.; Shen, L.; Hong, Y. Status and future scope of hydrogels in wound healing: Synthesis, materials and evaluation. Eur. Polym. J. 2020, 130, 109609. [Google Scholar] [CrossRef]
- Arribas-Lopez, E.; Zand, N.; Ojo, O.; Snowden, M.J.; Kochhar, T. The Effect of Amino Acids on Wound Healing: A Systematic Review and Meta-Analysis on Arginine and Glutamine. Nutrients 2021, 13, 2498. [Google Scholar] [CrossRef]
- Ishida, Y.; Kuninaka, Y.; Nosaka, M.; Furuta, M.; Kimura, A.; Taruya, A.; Yamamoto, H.; Shimada, E.; Akiyama, M.; Mukaida, N.; et al. CCL2-Mediated Reversal of Impaired Skin Wound Healing in Diabetic Mice by Normalization of Neovascularization and Collagen Accumulation. J. Investig. Dermatol. 2019, 139, 2517–2527. [Google Scholar] [CrossRef]
- Zhang, H.Y.; Wang, K.T.; Zhang, Y.; Cui, Y.L.; Wang, Q. A self-healing hydrogel wound dressing based on oxidized Bletilla striata polysaccharide and cationic gelatin for skin trauma treatment. Int. J. Biol. Macromol. 2023, 253, 127189. [Google Scholar] [CrossRef]
- Qi, L.; Zhang, C.; Wang, B.; Yin, J.; Yan, S. Progress in Hydrogels for Skin Wound Repair. Macromol. Biosci. 2022, 22, e2100475. [Google Scholar] [CrossRef] [PubMed]
- Feng, Y.; Qin, S.; Li, H.; Yang, Y.; Zheng, Y.; Liu, H.; Yap, W.Y.; Zhou, X.; Wen, J. Composite Hydrogel Dressings with Enhanced Mechanical Properties and Anti-Inflammatory Ability for Effectively Promoting Wound Repair. Int. J. Nanomed. 2023, 18, 5183–5195. [Google Scholar] [CrossRef] [PubMed]
- Issa-Zacharia, A. Application of Slightly Acidic Electrolyzed Water as a Potential Sanitizer in the Food Industry. J. Food Qual. 2024, 2024, 5559753. [Google Scholar] [CrossRef]

Disclaimer/Publisher’s Note: The statements, opinions and data contained in all publications are solely those of the individual author(s) and contributor(s) and not of MDPI and/or the editor(s). MDPI and/or the editor(s) disclaim responsibility for any injury to people or property resulting from any ideas, methods, instructions or products referred to in the content. |
© 2025 by the authors. Licensee MDPI, Basel, Switzerland. This article is an open access article distributed under the terms and conditions of the Creative Commons Attribution (CC BY) license (https://creativecommons.org/licenses/by/4.0/).
Share and Cite
Li, N.; Li, C.; Li, D.; Abbas, A.; Chen, X.; Ai, X.; Zhang, W.; Shu, G.; Lin, J.; Li, H.; et al. Combination of Slightly Acidic Electrolyzed Water and Hydrogel to Enhance Stability, Increase Antibacterial Efficacy, and Promote Infectious Wound Healing. Int. J. Mol. Sci. 2025, 26, 5908. https://doi.org/10.3390/ijms26125908
Li N, Li C, Li D, Abbas A, Chen X, Ai X, Zhang W, Shu G, Lin J, Li H, et al. Combination of Slightly Acidic Electrolyzed Water and Hydrogel to Enhance Stability, Increase Antibacterial Efficacy, and Promote Infectious Wound Healing. International Journal of Molecular Sciences. 2025; 26(12):5908. https://doi.org/10.3390/ijms26125908
Chicago/Turabian StyleLi, Nanxin, Chao Li, Dongbo Li, Awn Abbas, Xingyu Chen, Xiaoyang Ai, Wei Zhang, Gang Shu, Juchun Lin, Haohuan Li, and et al. 2025. "Combination of Slightly Acidic Electrolyzed Water and Hydrogel to Enhance Stability, Increase Antibacterial Efficacy, and Promote Infectious Wound Healing" International Journal of Molecular Sciences 26, no. 12: 5908. https://doi.org/10.3390/ijms26125908
APA StyleLi, N., Li, C., Li, D., Abbas, A., Chen, X., Ai, X., Zhang, W., Shu, G., Lin, J., Li, H., Xu, F., Peng, G., & Fu, H. (2025). Combination of Slightly Acidic Electrolyzed Water and Hydrogel to Enhance Stability, Increase Antibacterial Efficacy, and Promote Infectious Wound Healing. International Journal of Molecular Sciences, 26(12), 5908. https://doi.org/10.3390/ijms26125908

